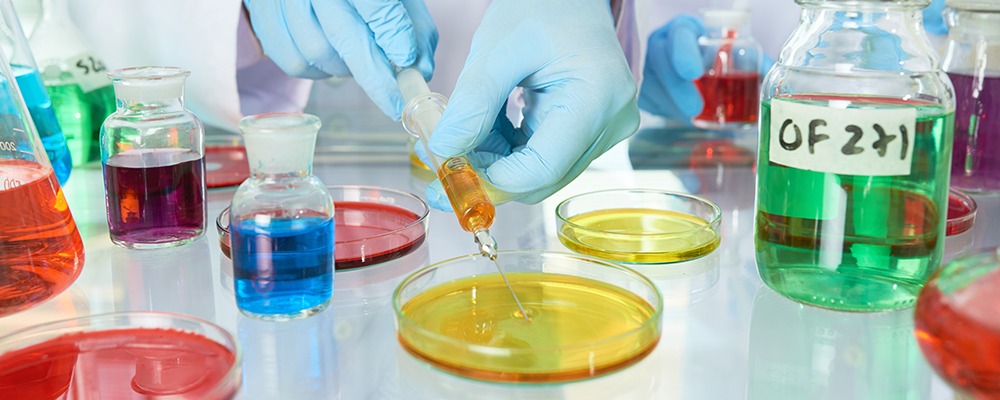

Cleaning, whether in industrial settings or domestic environments, is no longer limited to the traditional approach of using harsh chemicals and detergents. With advancements in biotechnology, enzymes have emerged as powerful, natural cleaning agents that offer efficiency, safety and environmental benefits. Among the most widely used enzymes in cleaning applications are protease, lipase and amylase. Each enzyme has its own specific function, but when combined in carefully designed formulations, they create a synergy that ensures comprehensive cleaning solutions across industries.
This blog explores how these enzymes function individually, the science behind their combined action, and why enzyme synergy has become an essential principle in the cleaning and detergent industry.
Understanding the Role of Protease
Protease enzymes specialise in breaking down proteins, which are among the most common types of stains encountered in cleaning. Blood, sweat, egg yolk, dairy and grass stains all contain proteins that form strong bonds with fabrics and surfaces. Traditional detergents often struggle to remove these residues completely, leaving dull marks or requiring multiple washes.
Protease works by hydrolysing the peptide bonds within protein molecules. This breaks them down into smaller, water-soluble fragments that can be easily washed away. In textiles, this process restores brightness and cleanliness while maintaining fabric integrity. In industrial cleaning, proteases are particularly useful in removing protein-rich deposits from surfaces in food and beverage processing units, healthcare settings and even wastewater systems.
The Power of Lipase
Lipase enzymes target fats and oils, which are notoriously difficult to clean. Grease stains on kitchen surfaces, fatty residues on industrial equipment, and oil-based stains on clothing are all rich in triglycerides. Lipase hydrolyses these triglycerides into glycerol and fatty acids, which are more soluble in water and therefore easier to remove.
In the food industry, lipase plays a vital role in maintaining hygiene standards by ensuring that greasy build-ups are completely broken down. In laundry detergents, it is especially effective against stains caused by butter, cooking oil, sauces and cosmetics. Lipase reduces the need for aggressive surfactants, making the cleaning process gentler on both fabrics and the environment.
The Versatility of Amylase
Starches are another common source of stains, especially in food-related industries and everyday laundry. Spilled pasta, rice, sauces thickened with flour, and even baby food contain starches that adhere strongly to fabrics and surfaces. Amylase enzymes are specialists in breaking down starch molecules into simple sugars that can be dissolved and rinsed away.
Amylase does not only help in removing starchy food stains but also improves the overall cleaning power of detergents by preventing redeposition of dirt particles. In the brewing industry and starch processing, amylase enzymes also play a crucial role in ensuring efficiency and product quality. This adaptability makes them valuable across different sectors.
Why a Combination Matters

Individually, protease, lipase and amylase each solve a particular cleaning challenge. However, stains are rarely made up of only one component. A single food spill may contain proteins from dairy or meat, fats from oil, and starches from rice or bread. A comprehensive cleaning solution must therefore target all three simultaneously.
This is where enzyme synergy comes into play. When combined, these enzymes work together to break down the full spectrum of organic matter. For example, lipase breaks down fats that may otherwise trap proteins and starches, making them less accessible. Protease dismantles protein barriers that can block the action of lipase and amylase. Amylase reduces starch residues that often bind oils and proteins together. Their combined effect ensures that stains are removed more effectively than by using any single enzyme.
Scientific Synergy: How It Works
The synergy of enzymes lies in their complementary modes of action. While protease cleaves peptide bonds, lipase hydrolyses ester bonds in fats, and amylase attacks glycosidic bonds in starch. These processes take place simultaneously when the enzymes are combined in a cleaning formulation. By reducing complex molecules into smaller, water-soluble fragments, the enzymes enhance the performance of detergents and reduce reliance on harsh chemical additives.
Another key aspect is the ability of enzymes to work at relatively mild temperatures and neutral pH levels. This not only makes them energy efficient but also preserves the integrity of fabrics and surfaces. The result is complete cleaning that is both effective and sustainable.
Industrial Applications of Enzyme Synergies
- Laundry Detergents
Modern laundry detergents often contain all three enzymes, enabling them to remove a wide variety of stains in a single wash. This reduces the need for hot water cycles, saving energy and prolonging fabric life.
- Food Processing Plants
In industries where hygiene is paramount, enzyme-based cleaning helps remove protein, fat and starch residues from processing equipment. This prevents microbial growth and ensures compliance with food safety regulations.
- Healthcare and Pharmaceuticals
Medical textiles and instruments often encounter protein-based contaminants. Enzyme combinations provide a safer alternative to strong chemicals, ensuring effective sterilisation while reducing damage to materials.
- Wastewater Treatment
Enzyme formulations are increasingly being explored in wastewater treatment for breaking down organic contaminants. The combined action of protease, lipase and amylase accelerates the degradation of organic matter, improving efficiency.
- Domestic Cleaning
From dishwashing to surface cleaning, enzyme-based products are gaining popularity among environmentally conscious consumers. The synergy of enzymes ensures sparkling cleanliness without the drawbacks of traditional chemicals.
Sustainability and Safety Benefits
The use of enzyme synergies in cleaning aligns with the growing demand for eco-friendly solutions. Since enzymes are biodegradable and effective at low concentrations, they reduce the chemical load released into the environment. Their ability to function at moderate temperatures lowers energy consumption, contributing to sustainability goals. Additionally, enzyme-based cleaners are generally safer for human health compared to aggressive chemical cleaners.
The reduction in harsh chemical usage also extends the lifespan of fabrics, machinery and equipment, providing both economic and environmental benefits. Enzyme synergies thus represent not just a scientific advancement but also a practical approach to achieving sustainable cleaning.
Future Directions
Research and development in enzyme technology continues to evolve, focusing on creating more stable and robust enzyme formulations that can withstand different pH levels and temperatures. Immobilisation techniques, where enzymes are attached to solid supports, are further enhancing their reusability and efficiency. Enzyme engineering is also opening doors to tailor-made variants with higher activity and specificity.
In the years ahead, the role of enzyme synergies in cleaning is expected to expand into new industries, supporting both performance-driven and eco-conscious objectives.
Conclusion
The science of cleaning is undergoing a profound transformation, shifting away from chemical-heavy methods towards biological solutions that are effective, safe and sustainable. Protease, lipase and amylase each play an important role in addressing specific cleaning challenges, but their combined action unlocks a new level of performance. By working together, these enzymes ensure that proteins, fats and starches are completely broken down, delivering spotless results across diverse applications.
At Biolaxi Enzymes, we understand the power of enzyme synergies and continue to design advanced formulations that harness the strengths of protease, lipase and amylase. With a strong focus on research, customisation and eco-friendly solutions, we deliver high-quality enzyme products to industries worldwide. Our commitment is to provide effective, safe and sustainable cleaning solutions that not only meet but exceed industry expectations.
